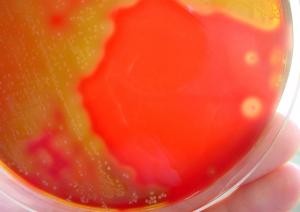
微生物写真②

本文
大分県衛生環境研究センター
新着情報
-
 2026年6月10日更新衛生環境研究センターフェアを開催します♪
2026年6月10日更新衛生環境研究センターフェアを開催します♪ -
 2026年3月5日更新酸性雨について
2026年3月5日更新酸性雨について -
 2026年2月25日更新微小粒子状物質(PM2.5)について
2026年2月25日更新微小粒子状物質(PM2.5)について
お知らせ
 公式Instagramができました
公式Instagramができました
大分県衛生環境研究センターの公式インスタグラムができました!
フォローお待ちしています♪
https://www.instagram.com/oita_eiken/


詳しくはこちらをご覧ください!⬇️
衛生環境研究センターについて
近年の保健衛生、環境分野は、令和元年12月中国に端を発した新型コロナウイルス感染症を始め、デング熱等の感染症や食品中の残留農薬、大気中の微小粒子状物質をはじめとする有害物質、また、「おんせん県おおいた」の温泉資源の保護や海、河川等の水環境などへの取組が求められています。
こうした中で、当センターは、保健衛生と環境分野の科学的・技術的中核機関として、これらの課題に対して、新型コロナウイルス感染症のpcr検査を含む様々な試験検査や調査研究を行っています。
今後も、大分県長期総合計画「安心・元気・未来創造ビジョン2024」~新しいおおいたの共創~に基づき、県民の健康被害の極小化と安全・安心な生活環境の確保のため、様々な課題に取り組んでいます。
企画・管理担当

高度化・広域化する諸課題に対応できるよう、職員の専門的な知識や技術力の習得・向上のため、専門研修派遣や調査研究の総合調整・評価などを行っています。
また、県民の当センター業務等の理解や環境保全の意識を図る体験学習、研修や広報を行っています。
化学担当


食品の残留農薬、動物用医薬品、食品添加物等の試験検査を行い、食品の安全性確保に努めています。
また、医薬品、家庭用品などの試験検査を行っています。
微生物担当

新型コロナウイルス感染症のPcr検査を含む感染症検査、食中毒の病原微生物学的検査や日本脳炎の流行予測調査を行っています。
また、レジオネラ菌や日本紅斑熱、sftsなどに関する調査研究を行い、保健衛生上の安全確保に努めています。
大気・特定化学物質担当


有害大気汚染物質、悪臭物質、環境放射能、酸性雨の測定及びPM2.5の成分分析を行っています。
また、大気汚染常時監視テレメータシステムと大気環境測定車で大気汚染状況の監視を行い大気環境の保全に努めています。
水質担当


県下の河川水、湖沼水、地下水、工場排水、廃棄物最終処分場からの放流水等及び温泉水の水質分析を行っています。
また、水質汚濁等に係る調査研究を行い、水質環境の保全に努めています。
お問い合わせ先
大分県衛生環境研究センター
〒870-1117 大分市高江西2丁目8番
| 代表 |
TEL:097-554-8980 Fax:097-554-8987 Mail:a13002@pref.oita.lg.jp |
|---|---|
| 化学担当 | 097-554-8983 |
| 微生物担当 | 097-554-8984 |
| 大気・特定化学物質担当 | 097-554-8982 |
| 水質担当 | 097-554-8986 |






